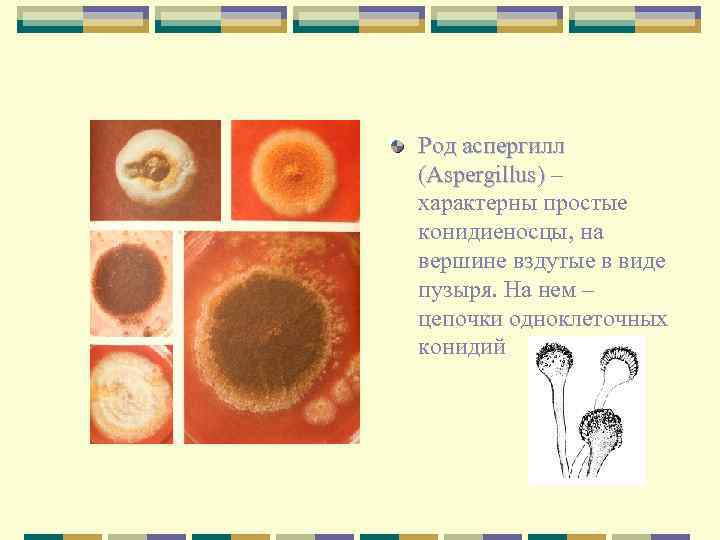
Род аспергилл (Aspergillus) – характерны простые конидиеносцы, на вершине вздутые в виде пузыря. На

БОТ(II)_Л 4_Грибы (сист.).ppt
- Количество слайдов: 41

Лекция 3 (II) Систематика грибов 1. 2. 3. 4. Оомицеты Зигомицеты Аскомицеты Базидиомицеты

Пункты программы по биологии 1. Класс Оомицеты. Особенности мицелия и полового процесса. Порядки сапролегниевые и пероноспоровые. Представители, образ жизни, заболевания, вызываемые оомицетами и меры борьбы с ними. 2. Класс Зигомицеты. Общая характеристика. Порядок Мукоровые. 3. Класс Аскомицеты. Общая характеристика. Подкласс Гемиаскомицеты. Подкласс Эуаскомицеты. Порядок Эвроциевые. Группа порядков Пиреномицеты: порядки эризифовые, сферейные, спорыньевые. Группа порядков Дискомицеты. Порядки пецициевые, хелоциевые. 4. Класс Базидиомицеты. Общая характеристика, деление на подклассы. Подкласс Холобазидиомицеты. Группа порядков гименомицеты. Порядки Афиллофоровые, Агариковые. Группа порядков гастеромицеты. Подкласс Телиобазидиомицеты. Порядки головневые и ржачинные. Основные представители, циклы развития. Значение в хозяйстве человека, меры борьбы с ними.

1. Класс Оомицеты (Oomycetes) • Оомицеты имеют хорошо развитый неклеточный • • мицелий (сифонального строения); клеточная стенка содержит целлюлозу и глюканы; размеры грибов – от микро до макроскопических; обитают на растительных остатках, трупах животных, в почве (сапротрофы); много паразитических форм; бесполое размножение происходит с помощью зооспор с двумя жгутиками: перистым и гладким; в размножении – основная тенденция – замена подвижных спор (у более примитивных водных оомицетов) неподвижными спорами (у более эволюционно-прогрессивных наземных форм оомицетов).

Порядок Сапролегниевые (Saprolegniales) 1. 2. Имеют зооспоры двух видов, морфологически различающихся между собой – грушевидные и почковидные. Явление называется дипланетизмом и способствует увеличению способности гриба к расселению. Зооспорангий – конечная, отделенная перегородкой камера гифы. В ней развиваются грушевидные зооспоры. При выходе из зооспорангия они имеют два пути дальнейшего развития: могут оседать на субстрате и прорастать в новый мицелий; могут оседать на субстрате, покрываться оболочкой, а затем давать не новую гифу, а морфологически другую зооспору – почковидной формы.

Особенности полового процесса. Антеридии сапролегниевых не дифференцированы на гаметы, а просто переливают часть своего содержимого с ядрами в оогоний с яйцеклетками. Представитель – сапролегния (Saprolegnia). Имеет гифы двух типов: ризоидальные, ветвящиеся, внедряющиеся в субстрат, и более толстые, неветвящиеся, растущих в стороны от субстрата. (Неветвящиеся гифы образуют белый пух вокруг трупов насекомых и другой мертвой органики, попавшей в воду, а также на теле зараженных прудовых или аквариумных рыб). Меры борьбы с сапролегнией в аквариуме – кормление рыб сбалансированным по питательным веществам кормом, добавление в воду метиленовой сини.

Порядок Пероноспоровые (Peronosporales) Низшие представители порядка живут в воде или почве, высшие – паразиты наземных растений. Соответственно этому у них выработались приспособления для расселения в природе по воздуху, воде (с помощью зооспор), при помощи животных и человека (на необезвреженных плодах и растительных остатках). Распространены практически по всему земному шару – от тропиков до полярного круга.

Тело состоит из более-менее разветвленной грибницы. Мицелий в начале развития несептированный, но впоследствии образует перегородки – при отделении старых участков гиф от нарастающих новых. Кроме того, всегда возникают перегородки, отделяющие органы спороношения. У сапротрофных видов грибница стелется по поверхности субстрата, у паразитных приурочена к жизни в организме хозяина. При половом размножении в оогонии возникает (в отличие от других оомицетов) только одна ооспора. Она имеет оболочку различной структуры – со складками, бугорками, сетчатую, шиповатую. Ооспоры не менее года пребывают в латентном состоянии в остатках пораженных растений, попавших в почву. Затем прорастают с образованием короткой гифы с зооспорангием, после чего начинается процесс бесполого размножения и новый цикл паразитирования.

Представители: Фитофтора (Phytophtora). Вызывает заболевание ложная мучнистая роса у пасленовых. Мицелий белый, паутинистый. Развивается в межклетниках, а в клетки хозяина проникают гаустории.

Пораженные участки быстро отмирают, на нижней стороне листьев картофеля, томатов образуются некротические коричневые пятна с белой каймой. Кайма – высунувшиеся из устьиц лимоновидные зооспорангии. Они отрываются и разносятся ветром или брызгами дождя. Попадая в каплях воды на другие листья, зооспорангий разрывается, зооспоры прорастают, нити мицелия фитофторы внедряются через устьица в новые ткани листа. Цикл спороношения составляет 3 -4 суток.

Попадающие на землю спорангии заражают клубни картофеля, вызывая образование на них серых пятен и побурение ткани под пятнами. У томатов болезнь поражает листья и плоды. Меры борьбы с фитофторой – опрыскивание смесью медного купороса с известью (бордосская жидкость), севооборот (поскольку в почве без растения-хозяина споры долго не живут).

Питиум (Pythium). Вызывает белую гниль на плодах тыквенных, соприкасающ ихся с почвой. Меры борьбы – те же.

Плазмопара (Plasmopara). Вызывает белый налет на листьях и карликовость у подсолнечника, зонтичных. Меры борьбы – те же.

2. Класс Зигомицеты (Zygomycetes) • Почти все представители ведут наземный образ жизни. • Есть сапротрофы, есть паразиты, в том числе, - человека. • Мицелий многоклеточный или неклеточный, разделяющийся на клетки в зрелом состоянии.

Бесполое размножение – неподвижными спорангиоспорами (у более примитивных мукоровых грибов) или конидиями (у более эволюционно-прогрессивных родов мукоровых грибов). Половой процесс – зигогамия (слияние двух недифференцированных на гаметы гаметангиев). Зигомицеты существуют в двух отдельных половых формах – мужской и женской. Виды, обладающие такой особенностью, называются гетероталличными. Копулировать могут только гаметангии разных половых знаков (+ или – ).

• Представители: 1. Порядок Мукоровые (Mucorales), Род Мукор (Mucor). Сапротроф, питается растительными остатками. Образует белый или серый налет (плесень) на пищевых продуктах – хлебе, варенье, овощах. Значение: участвует в почвообразовании, активно разлагает белки растительных остатков, вызывая обогащение почвы аммонийным азотом. Некоторые мукоровые вызывают микозы легких, головного мозга и других органов человека и животных. Некоторые мукоровые грибы используются в азиатских странах в приготовлении продуктов – в качестве закваски (китайские дрожжи).

2. Порядок Энтомофторовые (Entomophthorales). Род Энтомофтора (Entomophthora). Паразит насекомых. Образует внутри тела насекомых слаборазветвленную грибницу, которая постепенно заполняет все тело насекомого под хитиновым покровом. Энтомофтору используют в качестве биологического оружия против насекомых.

3. Класс Аскомицеты (Ascomycetes) – сумчатые грибы Насчитывает более 30 тыс. видов. Размеры – от микроскопических (дрожжи) до крупных (сморчки, строчки). Клеточная стенка содержит хитин и глюканы.

Вегетативное тело – разветвленный гаплоидный мицелий с хорошо развитыми септами. У некоторых аскомицетов мицелий может распадаться на отдельные клетки или почковаться. Споры бесполого размножения (конидии) образуются на гаплоидном мицелии на конидиеносцах различного строения

При половом процессе – гаметангиогамии – образуются сумки (аски) с фиксированным числом аскоспор (обычно 8). У низших аскомицетов сумки образуются непосредственно на мицелии, а у высших – в плодовых телах. На основании отсутствия или наличия плодовых тел и способов их образования класс аскомицетов делят на 4 подкласса. Важнейшие – п/к Гемиаскомицеты (Голосумчатые) и п/к Эуаскомицеты.

Подкласс Гемиаскомицеты (Hemiascomycetidae) Примитивные аксомицеты. Сумки развиваются одиночно из зиготы без участия аскогенных гиф или слоем на мицелии. Представитель – дрожжи

Настоящий мицелий отсутствует, клетки размножаются почкованием. Дрожжи растут и размножаются с большой скоростью, вызывая при этом существенные изменения в окружающей среде. Вызывают процессы брожения, что используется в виноделии и хлебопекарном производстве. Кроме этого, дрожжи – модельный объект в радиобиологии, цитологии и генетике. Дрожжи используют в фармацевтическом производстве (из-за высокого содержания витаминов группы В), а также для получения экстрактов, используемых в качестве кормовых или пищевых добавок.

Подкласс Эуаскомицеты. Сумки образуются в настоящих плодовых телах – аскокарпах. Снаружи плодовые тела покрыты плотной покровной тканью из вегетативных гиф. Плодовые тела трех типов: клейстотеции, перитеции и апотеции. Размеры клейстотециев и перитециев обычно мелкие (1 -2 мм), размеры апотециев – от долей мм до 15 -20 см. Часто плодовые тела образуются не на мицелии, а на стромах различного размера, окраски и консистенции, состоящих из переплетенных гиф. Система эуаскомицетов основана на строении плодовых тел, строении сумок, наличии и характера стромы.

Порядок Эвроциевые (Eurotiales) Около 30 родов и 150 видов. Плодовые тела – клейстотеции. В распространении большинства эуроциевых существенную роль играет конидиальное спороношение. Большинство эуроциевых – сапротрофы на растительных субстратах.

Представители: род биссохламис (Byssochlamys) – почвенные грибы, а также плесени на гниющих фруктах и ботанических препаратах. Создают проблемы при консервировании и фиксации растительных материалов.
Род аспергилл (Aspergillus) – характерны простые конидиеносцы, на вершине вздутые в виде пузыря. На нем – цепочки одноклеточных конидий

Род пеницилл (Penicillum) – имеет конидиеносцы в виде кисточки Аспергилл и пеницилл – формальные роды. К ним относятся конидиальные стадии нескольких родов эвроциевых грибов.

Группа порядков Пиреномицеты Плодовые тела – перитеции, реже клейстотеции. Характерно активное освобождение аскоспор. Порядок Эризифовые (Erysiphales), или Мучнисторосяные грибы Грибы-паразиты. Большинство живет на поверхности различных органов растений, где развивается их белая, затемтемнеющая грибница со спороношениями. Питание – с помощью гаусториев, проникающих в ткани растений. К поверхности листьев грибница прикрепляется присосками – апрессориями. В цикле развития – две стадии: конидиальная и сумчатая. Плодовые тела – клейстотеции. Аскоспоры разлетаются после созревания и растрескивания клейстотеция.

Представители: Эризифе (Erysiphe) – мучнистая роса злаковых, табака, бобовых, свеклы, зонтичных и др. Меры борьбы – обработка препаратами, содержащими серу.

Подосфера (Podosphaera) – мучнистая роса плодовых деревьев семейства розоцветные. Борьба – обработка фунгицидами, обрезка больных веток.

Микросфера (Microsphaera) – мучнистая роса дуба, березы, жимолости, грецкого ореха.

Порядок Спорыньевые, или Клавицепсовые (Clavicipitales) Образуют перитеции в хорошо развитых стромах (телах, состоящих из плотно переплетенных гиф). Сумки длинные, цилиндрические, с утолщенной на вершине оболочкой. Аскоспоры нитевидные. Большинство представителей – паразиты на цветковых растениях, грибах и членистоногих.

Наиболее распространена спорынья пурпурная (Claviceps purpurea), развивающаяся на злаках и осоках. На пораженных растениях образуются склероции – плотные черно-фиолетовые рожки, состоящие из плотно переплетенных гиф. При уборке урожая склероции попадают в почву. Весной склероции прорастают: образуются розоватые стромы, на головках которых развиваются перитеции. Аскоспоры из перитециев попадают на рыльца пестиков или на основание завязи, где способны прорастать мицелием. В завязи образуется плотная масса мицелия, покрытая слоем конидиеносцев, образующих огромное количество мелких конидий, погруженных в капли «медвяной росы» . Она привлекает насекомых, которые переносят конидиеспоры на другие растения. Склероции образуются через 1 -2 недели после заражения.

Группа порядков Дискомицеты. Плодовые тела – апотеции. Аскоспоры освобождаются активно (кроме порядка трюфелевых, у которого освобождение спор происходит после разрушения покровов). Порядок Гелоциевые (Helotiales) Плодовые тела – апотеции размерами от 0, 02 мм до 2 -3 см – открываются в виде трещины или поры.

Обитают на различных растительных субстратах. Играют огромную роль в разложении лесного опада. Лишь немногие виды можно отнести к напочвенным сапротрофам. Есть паразиты.

Представители: Монилиния (Monilinia) – паразитирует на плодах брусники, фруктовых культур. Вначале плоды буреют, покрываются кольцами подушечек конидиеносцев, затем образуется склероции и плоды засыхают и чернеют. Склеротиния (Sclerotinia) – возбудитель белой гнили на корнях свеклы, моркови, на клубнях картофеля и кочанах капусты – при хранении.

Порядок Пецициевые (Pezizales) Сумки открываются крышечкой. Плодовые тела – апотеции типичного строения, диаметром от 1 мм до 10 см. Апотеции мясистой, студенистой или кожистой консистенции. Окраска – разнообразная. Большей частью сапротрофы. Лишь немногие могут паразитировать на растениях.

2 1. 2. 3. 1 3 4 4. Представители: Сморчок (Morshella), Пецица (Peziza), Дисцина (Discina), Саркосцифа (Sarcoscypha)

Класс Базидиомицеты (Basidiomycetes) Высшие грибы с многоклеточным мицелием. Около 30 тыс. видов. Многоклеточный мицелий с развитыми септами и пряжками. Половое спороношение – с помощью базидиоспор на особых выростах мицелия – базидиях.

Агариковые грибы. Вегетативная часть гриба – грибница в субстрате. Базидии образуют плодущий слой – гименофор (трубчатый, зубчатый, пластинчатый) – на нижней стороне шляпки. Бесполое размножение спорами отсутствует (как и у высших аскомицетов)

Трутовики Развиваются на ослабленных и мертвых древесных стволах. Дождевики Плодовые тела покрыты толстой оболочкой и содержат внутри камеры – глебы, покрытые базидиями. Когда гриб созревает, оболочка разрывается и многочисленные базидиоспоры распыляются в окружающую среду.

Головневые грибы – паразиты растений. Пораженные растения напоминают обгорелые головешки. Ржавчинные грибы – паразиты растений. Образуют подушечки различных оттенков оранжевого цвета.
БОТ(II)_Л 4_Грибы (сист.).ppt